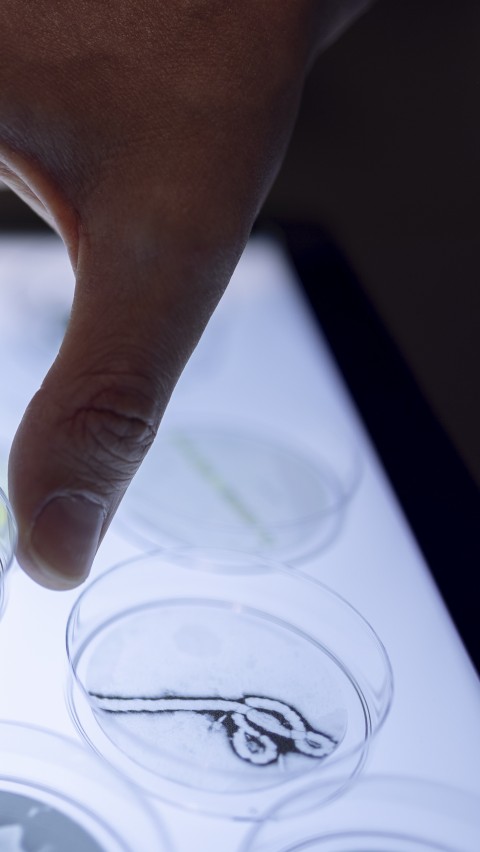
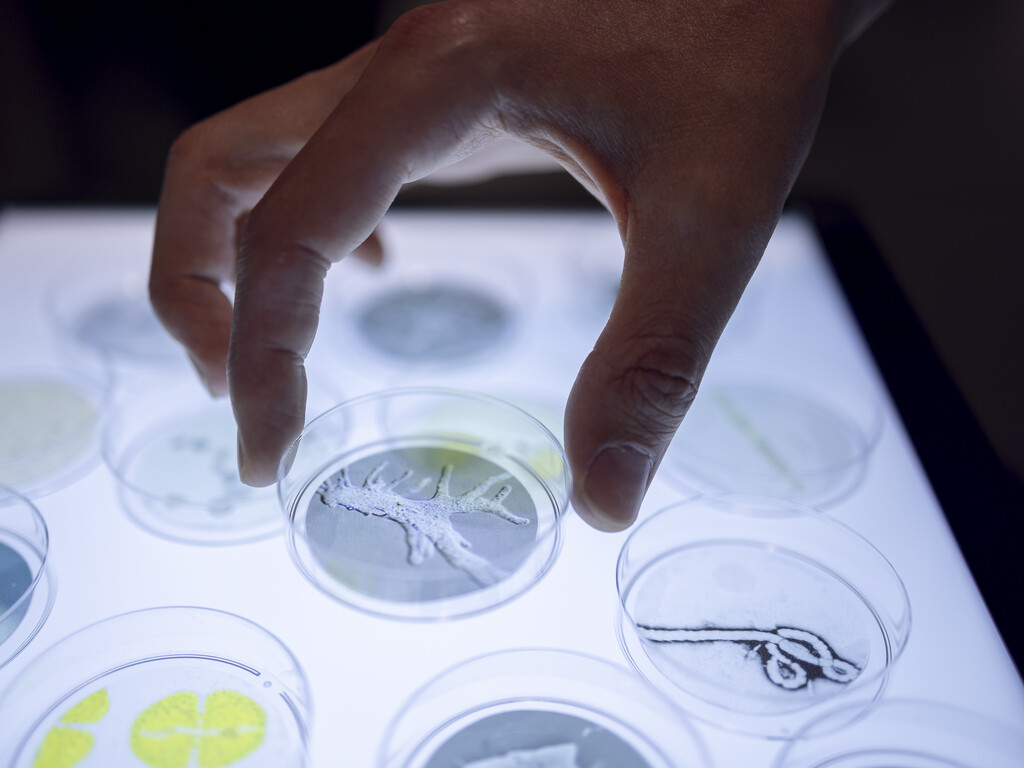

戸定邸 (千葉県松戸市)※トークはオンラインでも配信予定です
INVISIBLES:微生物たちの隠された世界
松戸から世界へ──市民参加型のアート&サイエンス・プロジェクト始動
スイス国立研究拠点(NCCRマイクロバイオーム)とスイス・ローザンヌに所在するミュゼ・ド・ラ・マンが共同で企画した展覧会「INVISIBLES:微生物たちの隠された世界」が、千葉県松戸市で開催される芸術祭「科学と芸術の丘2025」にて、他の魅力的なアート×サイエンスプロジェクトと共に、巡回展およびサテライト展示としてご覧いただけます。
この展覧会では、私たちの生活と密接に関わる微生物という、魅力的でありながらあまり知られていない世界を紹介します。微生物は遍在しながらも目に見えず、コミュニティ(マイクロバイオーム)を形成し、健康や環境において極めて重要な役割を担っています。地球上の生命の起源である微生物は、あらゆる生態系の均衡を支える存在でもあります。土壌から海、空気から植物、そして人間の体内に至るまで――展覧会は、来場者をその隠された世界を探訪する旅へと誘います
展示されている作品の一部は、スイス・ローザンヌのMusée de la main UNIL-CHUVにて、2024年6月27日から2026年1月4日まで開催された展覧会「INVISIBLES:微生物たちの隠された世界」から選出されたものです。本展は国立研究センターNCCRマイクロバイオームとの共同制作によるものです。
開催日時
2025年10月24日(金)10:00 〜 16:30
2025年10月25日(土)10:00 〜 16:30
2025年10月26日(日)10:00 〜 16:00 ※戸定邸入館受付は9:30〜16:30
「科学と芸術の丘2025」について

2025 開催テーマ
あなたは「 Δ 」を見て、何を思い浮かべますか?
多様性が広がる松戸の地で、見る人の数だけ異なるイメージが立ち上がる「Δ」を手がかりに、新たな未来を創造していきます。
芸術祭への参加方法
本芸術祭への参加方法の詳細はこちらから: https://science-art-matsudo.net/
NCCR マイクロバイオームは、自然界や健康のあらゆる側面における微生物群集の役割をより深く理解することを目的とした、スイス全土に広がる研究ネットワークです。このネットワークには、スイス全土から集まった25の研究チームで構成されており、ローザンヌ大学、チューリッヒ工科大学(ETH Zurich)、ローザンヌ連邦工科大学(EPFL)、チューリッヒ大学、ベルン大学、ローザンヌ大学病院(CHUV)が参加し、人間の感染症、動物の腸内および植物のマイクロバイオーム、ゲノミクスおよび計算生物学、応用・環境微生物学、微生物生態学および進化の分野で、国際的に高く評価される専門家を擁しています。2020年に設立されたNCCRマイクロバイオームは、スイス国立科学財団(SNSF)の支援を受けています。
サテライト展示パートナー

NCCR マイクロバイオーム(スイス)は、自然界や健康のあらゆる側面における微生物群集の役割をより深く理解することを目的とした、スイス全土に広がる研究ネットワークです。このネットワークには、スイス全土から集まった25の研究チームで構成されており、ローザンヌ大学、チューリッヒ工科大学(ETH Zurich)、ローザンヌ連邦工科大学(EPFL)、チューリッヒ大学、ベルン大学、ローザンヌ大学病院(CHUV)が参加し、人間の感染症、動物の腸内および植物のマイクロバイオーム、ゲノミクスおよび計算生物学、応用・環境微生物学、微生物生態学および進化の分野で、国際的に高く評価される専門家を擁しています。2020年に設立されたNCCRマイクロバイオームは、スイス国立科学財団(SNSF)の支援を受けています。

ミュゼ・ド・ラ・マン(通称:手の博物館・スイス ローザンヌ)は、科学文化に特化した学際的な施設で、五感を活かしたインタラクティブなテーマ展示を提供しています。文化的対話と市民参加に力を入れるこの場は、知識と経験が集まり、現代の課題を学際的に考察する機会を来館者に提供します。また、私たちの身体や認識を形づくる活動や知識を探求する場でもあります。没入型かつインタラクティブな展示を通じて、この博物館は好奇心旺盛な人々が集う拠点となっています。各展示では、すべての人を対象としたイベント、トーク、ディベートなどのプログラムが併せて行われます。

MISAF Labは、「科学と芸術の丘(Matsudo International Science Art Festival: MISAF)」のコアメンバーを中心とする研究開発チームです。バイオロジー、エコロジー、都市計画、社会連携、アート、デザイン、演劇など、分野横断的で多様な専門性を持つメンバーから構成されています。アートとサイエンスの幅広いパートナーと協働し、プロジェクトの立ち上げから実装、発表、社会対話に至るまでのプロセスを通じて、国内外の社会課題に創造的に取り組むとともに、未来社会への貢献を目指しています。

在日スイス大使館・科学技術部は、教育・研究・イノベーション分野において、スイスと日本を結ぶ役割を担っています。大学、研究機関、スタートアップ、スタートアップ支援機関、オープンイノベーションの担い手、政府機関などの多様な関係者をつなぎ、特に好奇心や創造性、活力と柔軟な発想を持つ精神に基づいた取り組みを後押しすることで、知識・アイデア・人材の国際的な連携を推進しています。分野や文化の垣根を越えた交流を推進し、スイスの強みを国際的に発信するとともに、革新的な発想や持続的なパートナーシップが生まれる環境を支えています。
助成
サカエ・シュトゥンツィ基金

ストーリーのカバー:
© Musée de la main UNIL-CHUV, Lausanne, Switzerland